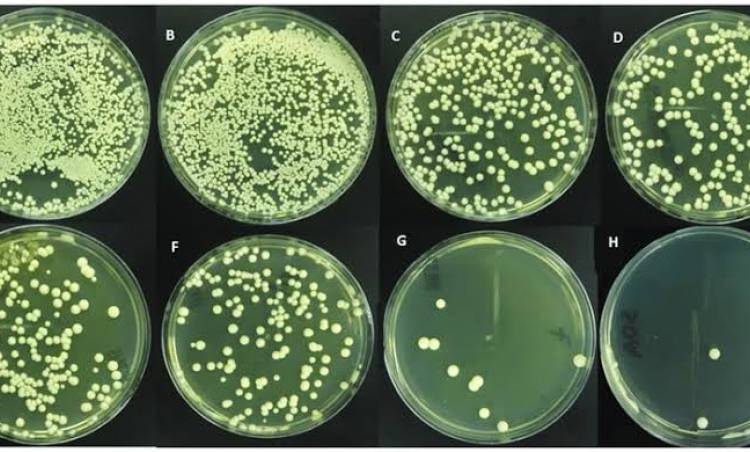

Candida neden olur? İşte bağırsak mantarının 18 nedeni
Candida albicans olarak da bilinen bağırsak mantarı sağlığınızı olumsuz yönde etkileyen bir mantar türüdür.
Peki candida neden olur?
Bağırsak florasının sağlıklı olması demek sizin sağlıklı olduğunuzu gösterir. Fakat bağırsak florası bozulursa pek çok hastalık ortaya çıkar.
Bağırsak florasının bozulmasıyla ortaya çıkan durumlardan biri de candida albicans olarak bilinen bağırsak mantarıdır.
Bağırsak florasının önemini her geçen gün vurgulayan Dr. Hüseyin Nazlikul, M.D., PhD. bağırsak mantarının da nedenlerini açıkladı.
İşte candidanın 18 nedeni
1) Bozulan bağırsak florası
2) İlaç ve özellikle antibiyotik kullanımı
3) Bağışıklık sisteminin zayıflaması
4) Sindirim saldılarının primer veyaz sekonder azlığı
5) Aşırı stres ve gerginlik
6) Sağlıksız beslenme
7) Rafine şeker, alkol ve tatlıların fazla tüketimi
8) Ağız ve diş sağlığının bozuk olması
9) Yeterince su içmemek
10) Kalitesiz uyku, uyku bozukluğu
11) Hormonal disfonksiyon
12) Yoğun elektrosmoga maruz kalmak
13) Besinlere karşı hassasiyet, besin alerjisi
14) Stres
15) Bedensel aktivite eksikliği
16) Adipositaz
17) Diyabet hastalığı
18) Bozucu alanlar